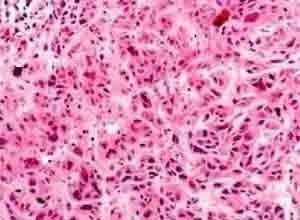

增蚀细胞,增蚀细胞生成机制解析
你知道吗?在科学的世界里,总有一些神奇的现象让人不禁想一探究竟。今天,我就要带你走进一个充满奥秘的领域——增蚀细胞。这些小小的细胞,看似不起眼,却能在人体内掀起一场翻天覆地的“战争”。准备好了吗?让我们一起揭开增蚀细胞的神秘面纱!
增蚀细胞:什么是它们?

首先,得先弄清楚增蚀细胞究竟是个啥。增蚀细胞,顾名思义,就是那些既能增生又能侵蚀的细胞。它们在人体内扮演着双重角色,既可以帮助修复受损的组织,又可能引发疾病。听起来是不是有点矛盾?别急,接下来我会详细解释。
增蚀细胞:增生的一面

增蚀细胞的第一面,是它们强大的增生能力。当我们的身体受到损伤时,增蚀细胞就会迅速行动起来,开始增生。它们像勤劳的小蜜蜂,一个接一个地分裂,形成新的细胞,填补受损的组织。这个过程,就是我们常说的“愈合”。
你知道吗?增蚀细胞在愈合过程中,还会分泌一种叫做“生长因子”的物质。这种物质可以促进其他细胞的生长和分裂,加快愈合速度。所以,增蚀细胞在人体内可是起着至关重要的作用呢!
增蚀细胞:侵蚀的一面
增蚀细胞并非总是那么“善良”。当它们增生过度时,就会变成“坏小子”,开始侵蚀周围的正常组织。这时,增蚀细胞就变成了引发疾病的“罪魁祸首”。
最常见的例子就是癌症。在癌症患者体内,增蚀细胞失去了控制,疯狂增生,侵蚀正常组织,甚至扩散到其他部位。这就是为什么癌症如此可怕的原因之一。
那么,增蚀细胞为什么会失控呢?研究发现,这与基因突变有关。当基因发生突变,增蚀细胞就会失去正常生长的调控,从而变得疯狂增生。
增蚀细胞:研究进展
近年来,科学家们对增蚀细胞的研究取得了重大进展。他们发现,通过抑制增蚀细胞的增生,可以延缓癌症的发展。这为治疗癌症带来了新的希望。
此外,科学家们还发现,增蚀细胞在愈合过程中,可以分泌一种叫做“细胞因子”的物质。这种物质可以促进免疫细胞的活性,提高人体免疫力。因此,增蚀细胞在人体内还具有免疫功能。
增蚀细胞:未来展望
随着科学技术的不断发展,相信我们对增蚀细胞的了解会更加深入。未来,科学家们有望找到更多关于增蚀细胞的知识,为人类健康事业做出更大贡献。
增蚀细胞这个小小的细胞,既能在人体内发挥重要作用,又可能引发疾病。了解它们,对于我们预防和治疗疾病具有重要意义。让我们一起期待,科学家们能揭开增蚀细胞的更多奥秘,为人类健康保驾护航!
您可以还会对下面的文章感兴趣:
暂无相关文章



